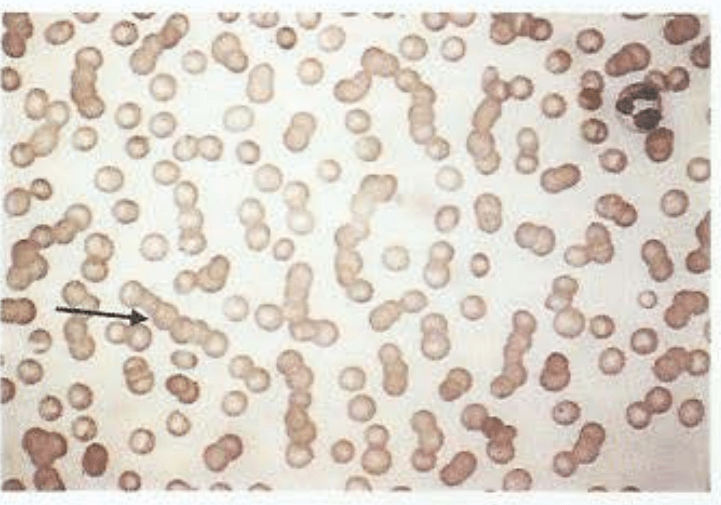
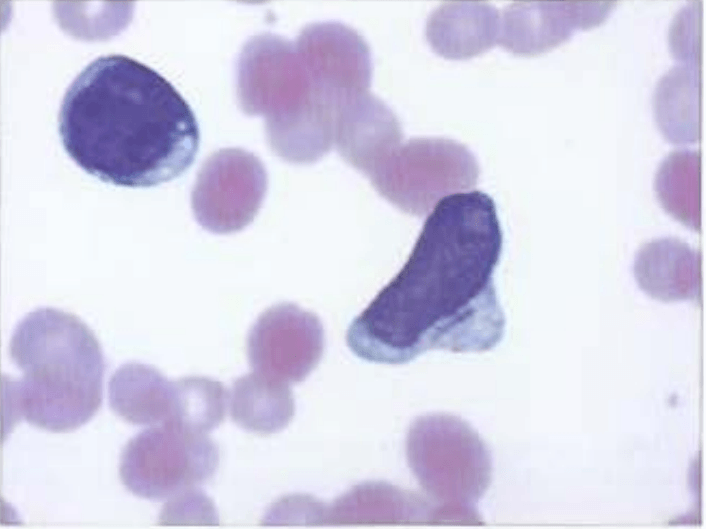

This acquired hematopoietic stem cell disorder is characterized by severely decreased bone marrow and pancytopenia.
What is aplastic anemia?
The M protein in plasma cell dyscrasias can be screened with this test
What is SPEP or UPEP
- points for either one
- confirm w/FLC after
The differential for microcytic anemia includes one of these two anemias
(points for either 1)
What is IDA or Thalassemia

The immunoglobulin class in Cold Agglutinin disease
What is IgM
- Warm weather is Great (IgG= warm agglutinin disease)
The only curative treatment for myelodysplastic syndrome
What is allogenic hematopoietic stem cell transplantation
- hypomethylating agents only reduce progression to AML
This is one of the many causes of pure red cell aplasia
What is:

This disease is characterized by proteinuria, restrictive cardiomyopathy causing diastolic heart failure, hepatosplenomegaly with evidence of portal hypertension, carpal tunnel syndrome, and macroglossia
What is AL Amyloidosis


Low MCV + elevated RDW + PBS showing microcytosis + anisopoikilocytocis is pathognomonic for which disease?
IDA

Name a disease which may have target cells
HALT for the target
H: HbC (hemoglobin C) disease
A: Asplenia
L: Liver disease
T: Thalassemia
This is the translocation causing CML
9:22
- long arms
- will also accept Philadelphia chromosome, BCR-ABL fusion gene (product of the translocation)
Clinically significant infections occur around this level of Neutrophil count, classified as severe neutropenia
What is < 500 uL
1000-1500 mild
500-1000 moderate
This formation is seen in pt's with MM
Rouleux formation
- also points for "erythrocytes (or RBC's) stacked on one top of another"
MCV 72-100 + low serum iron + low TIBC (< 250) + elevated ferritin classifies which class of anemia?
Inflammatory anemia

"Hook osteophytes" of particularly the 2nd and 3rd MCP joints, is pathognomonic for this disease

What is hereditary hemochromatosis?
- may also have DIP and PIP involvement
Therapy with this class of medications is required for all stages of CML
What are tyrosine kinase inhibitors?
- if you say Imatinib, Dasatinib, and Nilotinib, will accept too
This hematologic malignancy is contains a high amount of mature granulocytes (upper left), less mature myelocytes (bottom right), and metamyelocytes (top right). Basophils differentiate this disease from a leukemoid reaction.

What is CML?
Name one of the 3 risk factors for progression of MGUS to a clinically significant symptomatic plasma cell dyscrasia
(do NOT need exact values)

Microcytic anemia (60-70) + Hemoglobin 10-12 + isolated increase in alpha2 globulin on hemoglobin electrophoresis is the script for this disease
What is beta thalassemia?

The treatment for secondary iron overload
What is oral iron chelation therapy
ex: Deferasirox or Deferiprone
- therapeutic phlebotomy is contraindicated since they're anemic

Pruritus after a warm shower differentiates this cause of secondary erythrocytosis (> 16.5 g/dL hemoglobin) from other causes
What is polycythemia vera

This mutation is found in 97% of all pts with Polycythemia vera, 50% of all patients with essential thrombocytopenia and primary myelofibrosis
What is the Jak2 mutation?
This is the CRAB criteria for myeloma-related signs and symptoms
(all 4 required)
Hypercalcemia
Renal failure
Anemia
Bone disease (> 1 lytic lesion on imaging studies)
This treatment of paroxysmal nocturnal hemoglobinuria reduces complications and improves quality of life
What is Eculizumab, monoclonal antibody to C5

85% to 90% of patients with HH are homozygous for this mutation
- the mutation, not just the gene
What is the C282Y mutation
- in the HFE gene
The rod shaped inclusion body known as the Auer rod is seen in which disease?
Acute Myeloid Leukemia
tx: induction therapy w/anthracycline, infusional cytarabine, followed by consolidation therapy for responders. High risk= allogenic hematopoietic stem cells